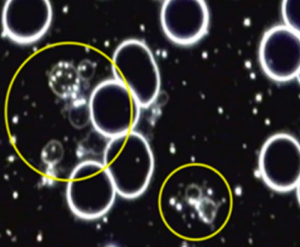

White, round, puffy forms in the plasma, appearing alone or in groups in brightfield. These are not easily visualized in darkfield and it is therefore advisable to look at the sample in brightfield first, before viewing it in darkfield. They appear as “bubbles” in darkfield (see “Thecits”).
Appearance
White, round, puffy forms in the plasma, appearing alone or in groups in brightfield. These are not easily visualized in darkfield and it is therefore advisable to look at the sample in brightfield first, before viewing it in darkfield. They appear as “bubbles” in darkfield (see “Thecits”).
Medical Perspective
Conventional medicine only recognizes localized Candida infections, such as oral and vaginal thrush, Candida of the nail (onychomycosis) and skin. The condition commonly referred to as “Candida” by alternative medicine, which is seen as a subclinical infection based on an overgrowth of Candida in the gastrointestinal tract, is not recognized by conventional medicine.
Pleomorphic Perspective
The common practice of referring to the small white spheres appearing in live blood in brightfield as yeast is a mistake. Fungal growth forms can not develop in the blood, since the blood’s pH is maintained by the body in an alkaline range and fungal organisms require an acidic environment to develop. These so-called yeasts are in fact thecits, mychits and colloid thecits in darkfield. These are all part of the bacterial phase of development, which develops in an alkaline environment. Candida itself can never be observed in its fungal phase in the blood because of the blood’s alkaline pH. It is a species that culminates in the fungal phase that may have a bacterial phase that is visible in the blood’s alkaline environment.
Similarly, the elongated forms referred to as fungal forms are also bacterial phase organisms, such as ascits, synascits, mychit chains and chondrits. These form part of the life cycle of the endobiont, which culminates in the fungus Mucor racemosus only after death. Only its various bacterial growth forms can be observed in live blood.
Relevance
These forms will appear in most blood samples due to the normal fermentation of sugars in the blood. However, they only begin to form approximately 10 minutes after the sample is prepared. The severity of a Candida case is assessed by how quickly and how many of these forms appear.
Implications
- Intestinal dysbiosis
- Overgrowth of Candida albicans in the intestinal tract
- Possible leaky gut syndrome
- Associated Symptoms:
- Fatigue
- Sugar Craving
- Blood sugar imbalance
- Bloating, Flatulence
- Irregular Bowel Movements
- Susceptibility to infections
- History of antibiotic, cortisone or oral contraceptive use
- Recurrent Thrush
- Rectal itching
- Itching of ears
- Fungal infections of the skin and/or nails
- Allergies
Interventions
Any combination of the following, depending on the rest of the case:
CANDIDA PROTOCOL (when due to Candida):
- Candecel + NeoFlora + HumiCaps (Neogenesis Health Products).
- Anti-Candida diet.
SUPPLEMENTS:
- Immune supporting nutritionals, such as Calcium ascorbate (2g 2xdaily), Zinc, N-Acetyl-Cysteine, proanthocyanidins & astaxanthin.
- Grapefruit seed extract
- Trace minerals: Bio-lonic Mineral Concentrate (Neogenesis Health Products).
GENERAL GUIDELINES:
- Increase water intake. To determine necessary daily water intake (in litres): Weight (kg)/8) x 0.25.
- Increase intake of fibre-rich carbohydrates (those tolerated by the blood type) and raw, polyunsaturated fats.
- Raw vegetable juices, sprouts, greens and antioxidant-rich superfoods.
- Avoid saturated fat, refined carbohydrates and food deficient in natural enzymes.
- Smokers: stop smoking
- Avoid alcohol, caffeine, sugar, drugs and non-essential medication.
Working With
Pleomorphists and conventional haematologists agree that Candida and yeast organisms can not be observed in the blood.
According to pleomorphists these forms are bacterial phase organisms such as thecits, mychits and colloid thecits. However, the presence of this morphology has been positively linked to Candida albicans overgrowth through antibody studies (Bradford/Ali, 1994). While it is incorrect to refer to these forms as yeast, their presence may be viewed as a biological marker for yeast overgrowth elsewhere in the body, especially Candida albicans in the intestines. This morphology is often seen in those whose beneficial intestinal floras have been destroyed by antibiotic treatment, cortisone, stress and diarrhoea.
When this morphology is observed, the presence of excessive sugar intake and mercury dental amalgams should be investigated and corrected as these often accompany Candida albicans. This condition does not respond favourably to the “Candida diet” alone and requires other interventions (outlined above) as part of a synergistic program. Many people end up being on a restricted diet indefinitely in an attempt to control the condition because they tried to treat it through diet alone.
A Candida infection is not created by dietary indiscretions alone and can therefore not be cured by special diets alone.